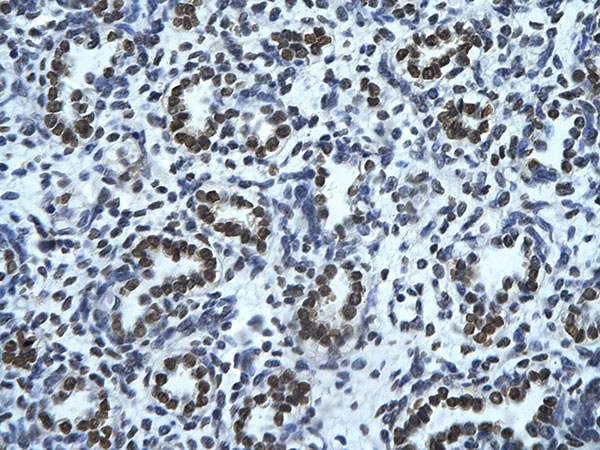

> Antigen, Antibodies, ELISA, Western Blot > Primary Antibody > Polyclonal Antibodies > HMGN1 antibody - middle regionBrand |
Leading Biology | Catalog Number |
APR12390G |
Product Type |
Polyclonal Antibodies | Field of Research |
|
Product Overview |
We constantly strive to ensure we provide our customers with the best antibodies. As a result of this work we offer this antibody in purified format.
We are in the process of updating our datasheets. If you have any questions regarding this update, please feel free to contact our technical support team.
This product is a high quality HMGN1 antibody - middle region.
|
||
Molecular Weight |
11 kDa
|
||
Cellular Localization |
Antigen Cellular Localization:
Nucleus. Cytoplasm. Note=Cytoplasmic enrichment upon phosphorylation. The RNA edited version localizes to the nucleus
|
||
Host |
Rabbit
|
||
Species Reactivity |
Human, Mouse, Rat, Rabbit, Pig, Dog, Guinea Pig, Horse, Bovine
|
||
Target |
Chromosomal protein HMG14 (HMGN1) and its close analog HMG17 (MIM 163910) bind to the inner side of the nucleosomal DNA, potentially altering the interaction between the DNA and the histone octamer. The 2 proteins may be involved in the process that maintains transcribable genes in a unique chromatin conformation. Their ubiquitous distribution and relative abundance, as well as the high evolutionary conservation of the DNA-binding domain of the HMG14 family of proteins, suggest that they may be involved in an important cellular function.Chromosomal protein HMG14 and its close analog HMG17 (MIM 163910) bind to the inner side of the nucleosomal DNA, potentially altering the interaction between the DNA and the histone octamer. The 2 proteins may be involved in the process that maintains transcribable genes in a unique chromatin conformation. Their ubiquitous distribution and relative abundance, as well as the high evolutionary conservation of the DNA-binding domain of the HMG14 family of proteins, suggest that they may be involved in an important cellular function.[supplied by OMIM]. Publication Note: This RefSeq record includes a subset of the publications that are available for this gene. Please see the Entrez Gene record to access additional publications.
|
||
Symbol |
HMG14
|
||
GeneID |
|||
UniProt ID |
|||
Function |
Binds to the inner side of the nucleosomal DNA thus altering the interaction between the DNA and the histone octamer. May be involved in the process which maintains transcribable genes in a unique chromatin conformation. Inhibits the phosphorylation of nucleosomal histones H3 and H2A by RPS6KA5/MSK1 and RPS6KA3/RSK2 (By similarity).
|
||
Summary |
This is a rabbit polyclonal antibody against HMGN1. It was validated on Western Blot using a cell lysate as a positive control. Abgent strives to provide antibodies covering each member of a whole protein family of your interest. We also use our best efforts to provide you antibodies recognize various epitopes of a target protein. For availability of antibody needed for your experiment, please inquire (sales@abgent.com).
|
||
Form |
Liquid. Purified antibody supplied in 1x PBS buffer with 0.09% (w/v) sodium azide and 2% sucrose. |
||
Storage & Stability |
Store at +4°C short term. For long-term storage, aliquot and store at -20°C or below. Stable for 12 months at -20°C. Avoid repeated freeze-thaw cycles.
|
||
Applications |
WB, IHC
|
||
Synonyms |
Non-histone chromosomal protein HMG-14, High mobility group nucleosome-binding domain-containing protein 1, HMGN1, HMG14
|
||
Images |

HMGN1 antibody - middle region (APR12390G) in Human Liver cells using Immunohistochemistry Immunohistochemistry with Human Liver cell lysate tissue at an antibody concentration of 5.0μg/ml using anti-HMGN1 antibody (APR12390G)
Human Lung Rabbit Anti-HMGN1 Antibody Paraffin Embedded Tissue: Human alveolar cell Cellular Data: Epithelial cells of renal tubule Antibody Concentration: 4.0-8.0 μg/ml Magnification: 400X 
HMGN1 antibody - middle region (APR12390G) in Human 721_B cells using Western Blot WB Suggested Anti-HMGN1 Antibody Titration: 0.2-1 μg/ml ELISA Titer: 1:312500 Positive Control: 721_B cell lysate HMGN1 is strongly supported by BioGPS gene expression data to be expressed in Human 721_B cells |
||
Specification |
|||
Quantity |
|
||
| Select | Brand | Catalog No. | Product Name | Pack Size | Type | Field of Research | Specification | Quantity | Price(USD) | |
| 1 | Leading Biology | APR03440G | ITGA11 Antibody (N-term) | 100 μl | Polyclonal Antibodies |
|
$495.00 | Add Ask | ||
| 2 | Leading Biology | APR04537G | CMIP Antibody (C-term) | 100 μl | Polyclonal Antibodies |
|
$495.00 | Add Ask | ||
| 3 | Leading Biology | APR12422G | Human H4 Histamine Receptor (extracellular) Antibody | 50 μl | Polyclonal Antibodies |
|
$695.00 | Add Ask | ||
| 4 | Leading Biology | APR03844G | UBE2W Antibody (C-term) | 100 μl | Polyclonal Antibodies |
|
$495.00 | Add Ask | ||
| 5 | Leading Biology | APR04349G | HECTD2 Antibody (N-term) | 100 μl | Polyclonal Antibodies |
|
$495.00 | Add Ask | ||
| 6 | Leading Biology | APR03502G | IGHG1 Antibody (Center) | 100 μl | Polyclonal Antibodies |
|
$495.00 | Add Ask |
 Leading Biology Inc.
2600 Hilltop DR, Building G, B Suite C138
Richmond, CA, 94806
Tel: 1-661-524(LBI)-0262
Email: info@leadingbiology.com
Leading Biology Inc.
2600 Hilltop DR, Building G, B Suite C138
Richmond, CA, 94806
Tel: 1-661-524(LBI)-0262
Email: info@leadingbiology.com
Complete this form and click send to ask us a question, request a quote or simply say hello.

You have 0 item in your cart

You have 0 item in your inquiry list
